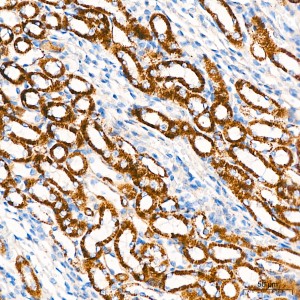
KD-Validated UQCRC1 Rabbit mAb (20 μl)

Your shopping cart is empty!
KD-Validated UQCRC1 Rabbit mAb (20 μl)
| Reactivity: | Human, Mouse, Rat |
| Applications: | WB, IHC, IF/IC, IP, ELISA |
| Host Species: | Rabbit |
| Isotype: | IgG |
| Clonality: | Monoclonal antibody |
| Gene Name: | ubiquinol-cytochrome c reductase core protein 1 |
| Gene Symbol: | UQCRC1 |
| Synonyms: | QCR1; PKNPY; UQCR1; D3S3191 |
| Gene ID: | 7384 |
| UniProt ID: | P31930 |
| Immunogen: | Recombinant fusion protein containing a sequence corresponding to amino acids 156-480 of human UQCRC1 (NP_003356.2). |
| Dilution: | WB 1:2000-1:12000; IHC 1:50-1:200; IF/IC 1:50-1:200 |
| Purification Method: | Affinity purification |
| Concentration: | 1.13 mg/ml |
| Buffer: | PBS with 0.09% Sodium azide, 0.05% BSA, 50% glycerol, pH7.3. |
| Storage: | Store at -20°C. Avoid freeze / thaw cycles. |
| Documents: | Manual-UQCRC1 monoclonal antibody |
Background
Enables ubiquitin protein ligase binding activity. Predicted to be involved in oxidative phosphorylation. Predicted to act upstream of or within mitochondrial electron transport, ubiquinol to cytochrome c. Located in mitochondrion. Implicated in Alzheimer's disease. Biomarker of Alzheimer's disease.
Images
 | Western blot analysis of lysates from wild type (WT) and UQCRC1 knockdown (KD) HeLa cells using [KD Validated] UQCRC1 Rabbit mAb (A26343) at 1:5000 dilution incubated overnight at 4℃. Secondary antibody: HRP-conjugated Goat anti-Rabbit IgG (H+L) (AS014) at 1:10000 dilution. Lysates/proteins: 25 μg per lane. Blocking buffer: 3% nonfat dry milk in TBST. Detection: ECL Basic Kit (RM00020). Exposure time: 10s. |
 | Western blot analysis of various lysates using [KD Validated] UQCRC1 Rabbit mAb (A26343) at 1:1000 dilution incubated overnight at 4℃. Secondary antibody: HRP-conjugated Goat anti-Rabbit IgG (H+L) (AS014) at 1:10000 dilution. Lysates/proteins: 25 μg per lane. Blocking buffer: 3% nonfat dry milk in TBST. Detection: ECL Basic Kit (RM00020). Exposure time: 10s. |
 | Immunohistochemistry analysis of paraffin-embedded Mouse kidney tissue using [KD Validated] UQCRC1 Rabbit mAb (A26343) at a dilution of 1:200 (40x lens). High pressure antigen retrieval performed with 0.01M Citrate Buffer (pH 6.0) prior to IHC staining. |
 | Immunohistochemistry analysis of paraffin-embedded Human liver tissue using [KD Validated] UQCRC1 Rabbit mAb (A26343) at a dilution of 1:200 (40x lens). High pressure antigen retrieval performed with 0.01M Citrate Buffer (pH 6.0) prior to IHC staining. |
 | Immunohistochemistry analysis of paraffin-embedded Human colon carcinoma tissue using [KD Validated] UQCRC1 Rabbit mAb (A26343) at a dilution of 1:200 (40x lens). High pressure antigen retrieval performed with 0.01M Citrate Buffer (pH 6.0) prior to IHC staining. |
 | Confocal imaging of HeLa cells using [KD Validated] UQCRC1 Rabbit mAb (A26343, dilution 1:200) followed by a further incubation with Cy3 Goat Anti-Rabbit IgG (H+L) (AS007, dilution 1:500) (Red). The cells were counterstained with α-Tubulin Mouse mAb (AC012, dilution 1:400) followed by incubation with ABflo® 488-conjugated Goat Anti-Mouse IgG (H+L) Ab (AS076, dilution 1:500) (Green). DAPI was used for nuclear staining (Blue). Objective: 100x. |
 | Immunoprecipitation of UQCRC1 from 600 µg extracts of Mouse liver tissue was performed using 1 µg of [KD Validated] UQCRC1 Rabbit mAb (A26343). Rabbit IgG isotype control (AC042) was used to precipitate the Control IgG sample. IP samples were eluted with 1X Laemmli Buffer. The Input lane represents 10% of the total input. Western blot analysis of immunoprecipitates was conducted using [KD Validated] UQCRC1 Rabbit mAb (A26343) at a dilution of 1:1000. |
You may also be interested in: